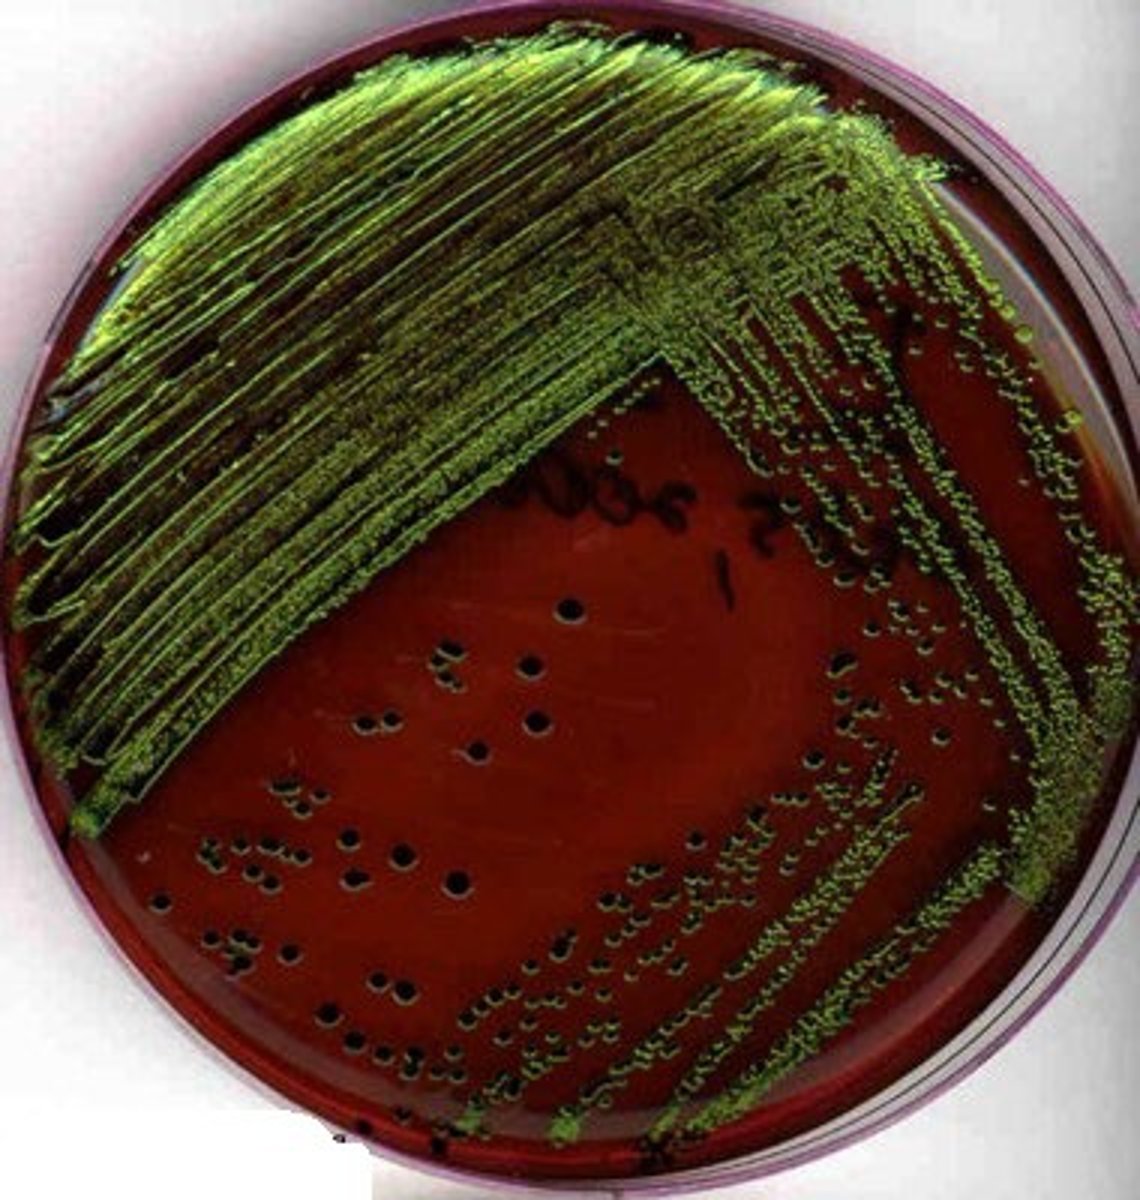
<p>which test is displayed in the picture?</p>

1/343
Name | Mastery | Learn | Test | Matching | Spaced |
|---|
No study sessions yet.
obligate aerobes
bacteria that require oxygen to live
obligate anaerobes
bacteria that are killed in the presence of oxygen
facultative anaerobes
bacteria that can use oxygen, but don't require oxygen to survive
aerotolerant anaerobes
bacteria that survive in both the presence and absence of oxygen; do not use oxygen
microaerophiles
bacteria that require oxygen to survive, but too much oxygen will kill them
capnophiles
bacteria that require extra carbon dioxide in their environment to survive
obligate aerobes
which bacteria is grown in this tube?


which bacteria is grown in this tube?
obligate anaerobes

which bacteria is grown in this tube?
facultative anaerobes
aerotolerant anaerobes
which bacteria is grown in this tube?


which bacteria is grown in this tube?
microaerophiles
which bacteria would grow best in a sealed jar with a burning candle?
capnophile
- moist heat: heat that uses water to kill bacteria
- dry heat: heat that only uses hot air to kill bacteria
what is the difference between moist heat and dry heat?
- moist heat: boiling, pasteurization, and autoclaving
- dry heat: dry oven and incineration
give examples of moist heat and dry heat
moist heat is most effective because the humidity better kills the microorganisms
which type of heat treatment is most effective (dry vs moist) and why?
- TDT: thermal death time; the lowest amount of time required to kill bacteria at a set temperature
- TDP: thermal death point: the lowest temperature required to kill bacteria in a set time
describe the difference between TDT and TDP
autoclaving: temperature of steam is raised to 121 degrees C by increasing the pressure on the steam to 15 psi and bacteria are killed in 15 minutes
what is the most effective method of moist heat sterilization? describe what happens in this procedure
UV can form pyrimidine dimers, which disrupt the DNA of bacteria
how does UV light kill bacteria?
when two thymines bind to each other in a DNA strand instead of binding to their complementary strand
*BE ABLE TO DRAW A THYMINE OR CYTOSINE DIMER!!*
describe a thymine dimer
t/f
UV light cannot penetrate surfaces, so it has to make direct contact with the microorganisms
t
what would happen if you accidentally left the lid to an agar dish while trying to kill the microorganisms with UV light?
the microorganisms would survive because the UV light can't penetrate through the lid
the minimum amount of time required to kill all bacteria of a given species with UV light
define minimum lethal dose
- disinfectants: chemical agents that KILL vegetative, pathogenic microorganisms on INANIMATE objects
- antiseptics: chemicals used on LIVING TISSUES to REDUCE the number of bacteria
describe the difference between disinfectants and antiseptics
lysol, pinsol, and chlorox
give examples of disinfectants that we used in lab
alcohol, hydrogen peroxide, and betadine
give examples of antiseptics that we used in lab
what is the difference between "static" and "cidal"
static: inhibits the growth of bacteria, cidal: kills bacteria
- antibiotics can be consumed
- antiseptics can only be used on the surface of our skin
what is the difference between antibiotics and antiseptics?
define MIC
minimum inhibitory concentration, the lowest concentration of an antibiotic that inhibits the growth of an organism
how do we determine the MIC of an organism?
testing for bacterial growth in different dilutions of the antibiotic in a liquid medium
to determine which antibiotics will be effective against a particular microorganism; if the bacteria is sensitive to a certain antibiotic, then a zone of inhibition will form
what do we use the Kirby-Bauer test for?
epidemiology
the study of the spread of disease
prevalence
the total number of people in a population who have a disease at a particular time, regardless of when they caught it or when they were diagnosed
(Total number of cases in the population)/(Total number of people in the population) x 100,000
prevalence rate
incidence
the number of new cases of disease that occur within a certain time period
(Number of new cases in the population) / (Number of people in the population) x 100,000
incidence rate
epidemic
when a disease is spreading rapidly in a particular population; it is localized
pandemic
when a disease is spreading rapidly globally or over more than one continent
endemic
when the prevalence is fairly stable in a location
sporadic disease
when a disease is spreading infrequently and in scattered locations
source case
the original patient responsible for transmitting the disease to others
why do we try to determine the source case?
to find out what is making everyone sick so that we can try to reduce the number of people getting sick
both;
- selective: chemical dyes inhibit growth of bacteria
- differential: lactose differentiates colonies of gram-negative
is EMB selective or differential? how?
is macconkey selective or differential?
both
what does a positive test look like for EMB? what about a negative test?
positive: dark green or purple color, negative: don't change color
what does a positive test look like for MacConkey? what about a negative test?
positive is pink, negative is colorless
- positive: turn yellow
- negative: stay red
- if it produces gas, then bubbles will form in the inverted tube
what does a positive test look like for Durham fermentation? what about a negative test?
what does a positive test look like for Methyl Red? what about a negative test?
positive is pink, negative stays yellow
what does a positive test look like for Voges-Proskauer? what about a negative test?
positive turns pink, negative stays yellow
what does TSIA stand for?
triple sugar iron agar
- red slant/red butt: negative for all sugars
- red slant/yellow butt: positive for Glucose only
- yellow slant/yellow butt: positive for glucose, lactose, and/or sucrose
- blackening: positive for hydrogen sulfide
tsia results
what does SIM stand for?
sulfide indole motility
- blackening: hydrogen sulfide is produced
- red ring forms at top of tube: indole is produced
- growth spreading away from injection site: motility is positive
what are the different results for a SIM test and what do they mean?
- positive: turns blue
- negative: stays green
what does a positive test look like for citrate utilization? what about a negative test?
what does a positive test look like for urease test? what about a negative test?
positive: turns bright pink, negative: stays orange
what does a positive test look like for oxidase test? what about a negative test?
positive- strip turns purple, negative- strip stays white
what does the oxidase test check for?
if the bacteria uses cytochrome oxidase during aerobic respiration
if the bacteria produces the enzyme urease so that urea will be broken down into ammonia
what does the urease test check for?
what does the citrate test check for?
if bacteria can use citrate alone as its carbon source
if acid is produced during glucose fermentation
what does the methyl red test check for?
for the production of 2,3-butylene glycol and acetoin from glucose
what does the Voges-Proskauer test check for?
if the bacteria can ferment the particular sugar tested and if gas is released as a byproduct
what does the durham test check for?
which test is displayed in the picture?
EMB agar

which test is displayed in the picture?
MacConkey agar
Durham fermentation tubes
which test is displayed in the picture?

Methyl Red test
which test is displayed in the picture?


which test is displayed in the picture?
Voges-Proskauer test
TSIA
which test is displayed in the picture?

SIM
which test is displayed in the picture?


which test is displayed in the picture?
Citrate utilization

which test is displayed in the picture?
urease utilization


which test is displayed in the picture?
Oxidase test

What are environmental factors that influence bacterial growth
Temperature, oxygen concentration, pH, and osmotic pressure
Oxygen serves as a _____ ______ acceptor in aerobic respiration
Terminal electron
Based on oxygen requirement, bacteria are grouped into five types:
Aerobes, microaerophiles, obligate anaerobes, aerotolerant anaerobes, facultative anaerobes, capnophiles
Aerobes
Use oxygen as their final electron acceptor in energy metabolism, must have oxygen to live
Obligate anaerobes
Use an inorganic molecule other than oxygen as their final electron acceptor, killed by the presence of oxygen
Facultative anaerobes
Can use oxygen, but does not require oxygen to grow
Microaerophiles
Require low concentrations of oxygen to grow
Aerotolerant anaerobes
Do not require oxygen, but can tolerate oxygen
Capnophiles
Require extra carbon dioxide in their environment
What are the methods to test for anaerobic growth of bacteria
Growth in thioglycolate tubes, growth in candle jars, growth in anaerogen bags, growth in incubator
What does thioglycolate do
Takes out oxygen in the agar medium
Candle jar reduced oxygen conditions
Solid sealed jar with candle in it, as candle burns it uses up some oxygen and creates co2
When happens in the candle jar when the candle flickers out
Co2 has risen from .4% to 4% and oxygen has dropped from 20% to 18%
Anaerogen system is a
Specifically designed pouch
Anaerogen system process
Place samples in the bag and insert activated anaerogen packet, anaerogen will remove all the oxygen in the bag to generate anaerobic conditions
Define and provide an example microbe: obligate anaerobe
A microbe that cannot survive in the presence of oxygen because oxygen is toxic to it. They lack enzymes that break down harmful oxygen radicals. Clostridium botulinum
Define and provide an example microbe: Obligate aerobe
A microbe that requires oxygen to survive because it uses oxygen for cellular respiration, oxygen acts as the final electron acceptor in the electron transport chain. Mycobacterium tuberculosis
Define and provide an example microbe: Facultative anaerobe
A microbe that cannot survive in grow with or without oxygen, but grows better with oxygen since aerobic respiration yields more atp. If oxygen isn’t available, it switches to fermentation or anaerobic respiration. Escherichia coli
Define and provide an example microbe: Microaerophile
A microbe that needs oxygen to survive, but only at low concentrations. High levels are toxic. Helicobacter pylori
Define and provide an example microbe: Capnophile
A microbe that thrives in environments rich in carbon dioxide, Neisseria gonorrhoeae
Why do aerobic organisms need oxygen
Aerobic organisms need oxygen because its essential for how they make energy, oxygen is the final electron acceptor, allows maximum atp yield, and cells cant survive long without it
Examples of strict aerobes
Neisseria and pseudomonas
Examples of obligate anaerobes
Clostridium and bacteroids
What do facultative anaerobes do when oxygen is present
They use aerobic respiration to break food molecules down further and obtain more ATP.
What do facultative anaerobes do when no oxygen is present
They proceed with anaerobic fermentation
Microaerophiles examples
Campylobacter and Micrococcus
Capnophile examples
Streptcoccus and hemophilus
What is a widely used method for controlling microorganisms
Heat
Moist heat examples
Boiling, pasteurization, autoclaving